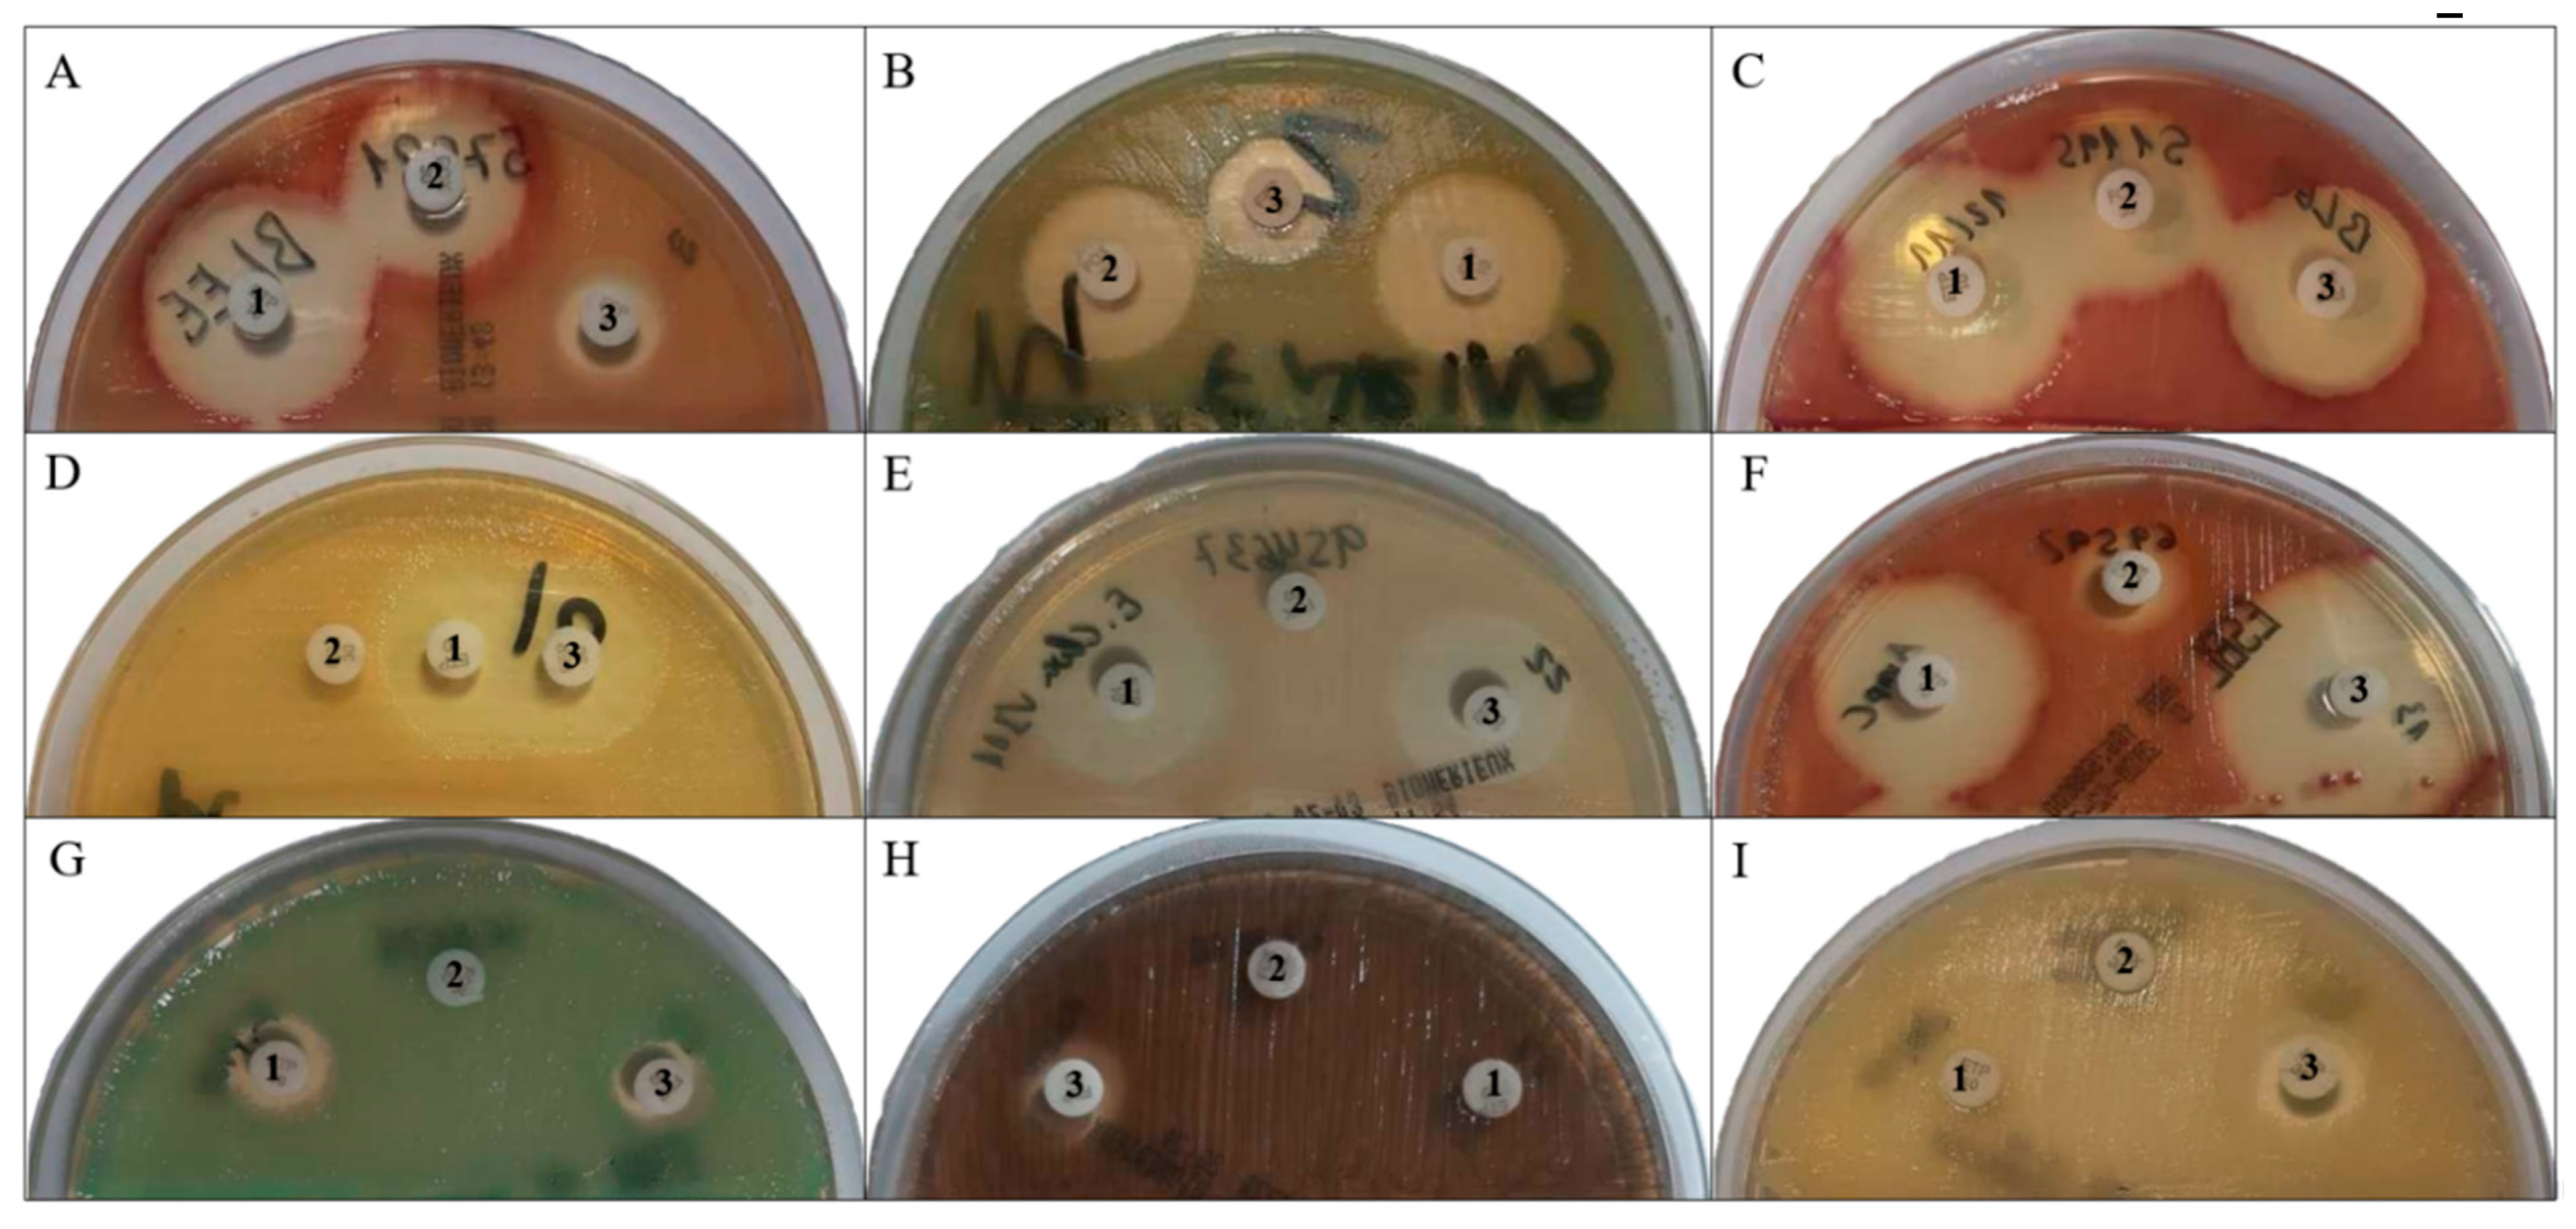
Microorganisms 08 01555 g001 Microorganisms 08 01555 g001

Clinical Relevance of Antibiotic Susceptibility Profiles for Screening Gram-negative Microorganisms Resistant to Beta-Lactam Antibiotics
Abstract
1. Introduction
2. Material and Methods
2.1. Studied Microorganisms
2.2. Investigation of Bacteria Growth on CHROMID ESBL Medium
2.3. Statistical Analysis
3. Results
3.1. Behavior of Susceptibility Profiles with CEF, FOX, and ERT Disks
3.1.1. Enterobacterales with ESBL
3.1.2. Enterobacterales with AmpC
3.1.3. Carbapenemase-producing microorganisms
3.2. Calculation of the Breakpoint with ERT and FEP for Carbapenemase-producing Microorganisms
3.2.1. Enterobacterales and ERT
3.2.2. Pseudomonas spp. and CEF
3.2.3. A. baumannii and CEF
4. Discussion
4.1. Susceptibility Profiles with CEF, FOX, and ERT Disks
4.2. Breakpoint Calculation with ERT and FEP for the Screening of Carbapenemase-producing Microorganisms
4.3. Study Limitations for Its Application in Clinical Practice
5. Conclusions
Author Contributions
Funding
Acknowledgments
Conflicts of Interest
References
- WHO. WHO Publishes List of Bacteria for Which New Antibiotics are Urgently Needed. Available online: https://www.who.int/news-room/detail/27-02-2017-who-publishes-list-of-bacteria-for-which-new-antibiotics-are-urgently-needed (accessed on 14 August 2020).
- Oteo, J.; Bou, G.; Chaves, F.; Oliver, A. Microbiological methods for surveillance of carrier status of multiresistant bacteria. Enferm. Infec. Microbiol. Clin. 2017, 35, 667–675. [Google Scholar] [CrossRef] [PubMed]
- Paniagua, R.; Valverde, A.; Coque, T.M.; Baquero, F.; Cantón, R. Assessment of prevalence and changing epidemiology of extended- spectrum β-lactamase-producing Enterobacteriaceae fecal carriers using a chromogenic medium. Diagn. Microbiol. Infect. Dis. 2010, 67, 376–379. [Google Scholar] [CrossRef] [PubMed]
- Del Castillo, M.C.; López-Cerezo, L.; Casal, M.; Pascual, A. Evaluation of chromID ESBL medium for detecting carriers of extended-spectrum beta-lactamase-producing Enterobacteriaceae. Enferm. Infecc. Microbiol. Clin. 2011, 9, 471–472. [Google Scholar] [CrossRef] [PubMed]
- Romo-Ibáñez, Á.; Calatrava-Hernández, E.; Gutiérrez-Soto, B.; Pérez-Ruiz, M.; Navarro-Marí, J.M.; Gutiérrez-Fernández, J. High clinical impact of rapid susceptibility testing on CHROMID ESBL® medium directly from swabs. Ann. Trans. Med. 2020, 8, e604. [Google Scholar] [CrossRef] [PubMed]
- Fresnadillo Martínez, M.J.; García García, M.I.; García Sánchez, E.; García Sánchez, J.E. Available carbapenems: Properties and differences. Enferm. Infecc. Microbiol. Clin. 2010, 28 (Suppl. 2), 53–64. [Google Scholar]
- Araújo, M.; Santos, C.M.; Lages, D. Carbapenem resistant Enterobacteriaceae—the basics for every medical specialty. Port. J. Nephrol. Hyp. 2019, 33, 176–181. [Google Scholar] [CrossRef]
- Peleg, A.Y.; Seifert, H.; Paterson, D.L. Acinetobacter baumannii: Emergence of a successful pathogen. Clin. Microbiol. Rev. 2008, 21, 538–582. [Google Scholar] [CrossRef]
- CLSI (Clínical and Laboratory Standards Institute). M100. In Performance Standards for Antimicrobial Susceptibility Testing, 30th ed.; CLSI: Annapolis Junction, MD, USA, 2020. [Google Scholar]
- Workneh, M.; Wang, R.; Kazmi, A.Q.; Chambers, K.K.; Opene, B.N.A.; Lewis, S.; Goodman, K.; Tamma, P.D.; Carroll, K.C.; Milstone, A.M.; et al. Evaluation of the direct macconkey method for identification of carbapenem-resistant gram-negative organisms from rectal swabs: Re-evaluating zone diameter cutoffs. J. Clin. Microbiol. 2019, 57, 12. [Google Scholar] [CrossRef] [PubMed]
- Pitout, J.D.D. Infections with extended-spectrum β-lactamase-producing Enterobacteriaceae. Drugs 2010, 70, 313–333. [Google Scholar] [CrossRef]
- Vardakas, K.Z.; Tansarli, G.S.; Rafailidis, P.I.; Falagas, M.E. Carbapenems versus alternative antibiotics for the treatment of bacteraemia due to enterobacteriaceae producing extended-spectrum β-lactamases: A systematic review and meta-analysis. J. Antimicrob. Chemother. 2012, 67, 2793–2803. [Google Scholar] [CrossRef]
- Pangon, B. In-vivo selection of a cephamycin-resistant, porin-deficient mutant of Klebsiella pneumoniae producing a TEM-3 β-lactamase. J. Infect. Dis. 1989, 159, 1005–1007. [Google Scholar] [CrossRef] [PubMed]
- Demonchy, E.; Courjon, J.; Ughetto, E.; Durand, M.; Risso, K.; Garraffo, R.; Roger, P.M. Cefoxitin-based antibiotic therapy for extended-spectrum β-lactamase-producing Enterobacteriaceae prostatitis: A prospective pilot study. Int. J. Antimicrob. Agents 2018, 51, 836–841. [Google Scholar] [CrossRef] [PubMed]
- Rupp, M.; Fey, P.D.; Rupp, M.E.; Fey, P.D. Extended spectrum β-lactamase (ESBL)-producing Enterobacteriaceae considerations for diagnosis, prevention and drug treatment. Drugs 2003, 63, 353–365. [Google Scholar] [CrossRef] [PubMed]
- Sorlozano, A.; Salmeron, A.; Martinez-Checa, F.; Villegas, E.; Luna, J.D.; Gutierrez, J. Low impact of OmpC and OmpF on susceptibility to antibiotics in clinical isolates of Escherichia coli producers of extended-spectrum beta-lactamases. In Antibiotic Resistance: Causes and Risk Factors, Mechanisms and Alternatives; Bonilla, A.R., Munizeds, K.P., Eds.; Nova Biomedical Books: New York, NY, USA, 2009; pp. 261–270. ISBN 978-1-60741-623-4. [Google Scholar]
- Flament-Simon, S.C.; Nicolas-Chanoine, M.H.; García, V.; Duprilot, M.; Mayer, N.; Alonso, M.P.; García-Meniño, I.; Blanco, J.E.; Blanco, M.; Blanco, J. Clonal structure, virulence factor-encoding genes and antibiotic resistance of Escherichia coli, causing urinary tract infections and other extraintestinal infections in humans in spain and france during 2016. Antibiotics 2020, 9, 161. [Google Scholar] [CrossRef] [PubMed]
- Dangelo, R.G.; Johnson, J.K.; Bork, J.T.; Heil, E.L. Treatment options for extended-spectrum beta-lactamase (ESBL) and AmpC-producing bacteria. Expert Opin. Pharmacoth. 2016, 17, 953–967. [Google Scholar] [CrossRef]
- Jiménez-Guerra, G.; Heras-Cañas, V.; Béjar Molina, L.D.C.; Sorlózano-Puerto, A.; Navarro-Marí, J.M.; Gutiérrez-Fernández, J. Extended-spectrum beta-lactamase-producing Escherichia coli and Klebsiella pneumoniae from urinary tract infections: Evolution of antimicrobial resistance and treatment options. Med. Clin. (Barc.) 2018, 150, 262–265. [Google Scholar] [CrossRef]
- Paterson, D.L.; Ko, W.; Von Gottberg, A.; Casellas, M.; Mulazimoglu, L.; Klugman, K.P.; Bonomo, R.A.; Rice, L.B.; Mccormack, J.G.; Yu, V.L.; et al. Outcome of cephalosporin treatment for serious infections due to apparently susceptible organisms producing extended-spectrum beta-lactamases. J. Clin. Microbiol. 2001, 39, 2206. [Google Scholar] [CrossRef]
- Patel, H.B.; Lusk, K.A.; Cota, J.M. The role of cefepime in the treatment of extended-spectrum beta-lactamase infections. J. Pharm. Pract. 2019, 32, 458–463. [Google Scholar] [CrossRef]
- Tzouvelekis, L.S.; Tzelepi, E.; Tassios, P.T.; Legakis, N.J. CTX-M-type β-lactamases: An emerging group of extended-spectrum enzymes. Int. J. Antimicrob. Agents 2000, 14, 137–142. [Google Scholar] [CrossRef]
- Livermore, D.M. Βeta-lactamases in laboratory and clinical resistance. Clin Microbiol Rev. 1995, 8, 557–584. [Google Scholar] [CrossRef]
- Jacoby, G.A. AmpC Β-Lactamases. Clin. Microbiol. Rev. 2009, 22, 161–182. [Google Scholar] [CrossRef]
- Bush, K.; Bradford, P.A. Epidemiology of β-Lactamase-Producing Pathogens. Am. Soc. Microbiol. 2020, 33, 1–37. [Google Scholar] [CrossRef] [PubMed]
- Miró, E.; Agüero, J.; Larrosa, M.N.; Fernández, A.; Conejo, M.C.; Bou, G.; González-López, J.J.; Lara, N.; Martínez-Martínez, L.; Oliver, A.; et al. Prevalence and molecular epidemiology of acquired AmpC β-lactamases and carbapenemases in Enterobacteriaceae isolates from 35 hospitals in Spain. Eur. J. Clin. Microbiol. Infect. Dis. 2012, 32, 253–259. [Google Scholar] [CrossRef] [PubMed]
- Jiménez-Guerra, G.; Borrego-Jiménez, J.; Gutiérrez-Soto, B.; Expósito-Ruiz, M.; Navarro-Marí, J.M.; Gutiérrez-Fernández, J. Susceptibility evolution to antibiotics of Enterobacter cloacae, Morganella morganii, Klebsiella aerogenes and Citrobacter freundii involved in urinary tract infections: An 11-year epidemiological surveillance study. Enferm. Infecc. Microbiol. Clin. 2020, 38, 166–169. [Google Scholar] [CrossRef] [PubMed]
- Shin, S.Y.; Bae, I.K.; Kim, J.; Jeong, S.H.; Yong, D.; Kim, J.M.; Lee, K. Resistance to carbapenems in sequence type 11 Klebsiella pneumoniae is related to DHA-1 and loss of OmpK35 and/or OmpK36. J. Med. Microbiol. 2012, 61, 239–245. [Google Scholar] [CrossRef]
- Tsai, Y.K.; Liou, C.H.; Fung, C.P.; Lin, J.C.; Siu, L.K. Single or in combination antimicrobial resistance mechanisms of Klebsiella pneumoniae contribute to varied susceptibility to different carbapenems. PLoS ONE 2013, 8, e79640. [Google Scholar] [CrossRef]
- Mairi, A.; Pantel, A.; Sotto, A.; Lavigne, J.P.; Touati, A. OXA-48-like carbapenemases producing Enterobacteriaceae in different niches. Eur. J. Clin. Microbiol. Infect. Dis. 2018, 37, 587–604. [Google Scholar] [CrossRef]
- López-Camacho, E.; Paño-Pardo, J.R.; Ruiz-Carrascoso, G.; Wesselink, J.J.; Lusa-Bernal, S.; Ramos-Ruiz, R.; Ovalle, S.; Gómez-Gil, R.; Pérez-Blanco, V.; Pérez-Vázquez, M.; et al. Population structure of OXA-48-producing Klebsiella pneumoniae ST405 isolates during a hospital outbreak characterised by genomic typing. J. Glob. Antimicrob. Resist. 2018, 15, 48–54. [Google Scholar] [CrossRef]
- Robustillo-Rodela, A.; Pérez-Blanco, V.; Espinel Ruiz, M.A.; Ruiz Carrascoso, G.; Figueira Iglesias, J.C.; Abad Martín, D. Successful control of 2 simultaneous outbreaks of OXA-48 carbapenemase-producing Enterobacteriaceae and multidrug-resistant Acinetobacter baumannii in an intensive care unit. Am. J. Infect. Control 2017, 45, 1356–1362. [Google Scholar] [CrossRef]
- Ayoub Moubareck, C.; Halat, D.H. The current burden of carbapenemases: Review of significant properties and dissemination among. Antibiotics 2020, 9, 186–220. [Google Scholar]
- Wu, W. NDM metallo-beta-lactamases and their bacterial producers in health care settings. Clin. Microbiol. Rev. 2019, 32, 115–118. [Google Scholar] [CrossRef] [PubMed]
- Pitout, J.D.D.; Peirano, G.; Kock, M.M.; Strydom, K.A.; Matsumura, Y. The global ascendency of OXA-48-type carbapenemases. Clin. Microbiol. Rev. 2020, 33, 1–48. [Google Scholar] [CrossRef] [PubMed]
- Walther-Rasmussen, J.; Høiby, N. Class A carbapenemases. J. Antimicrob. Chemother. 2007, 60, 470–482. [Google Scholar] [CrossRef] [PubMed]
- Soria-Segarra, C.; Soria-Segarra, C.; Catagua-González, A.; Gutiérrez-Fernández, J. Carbapenemase producing Enterobacteriaceae in intensive care units in Ecuador: Results from a multicenter study. J. Infect. Public Health 2020, 13, 80–88. [Google Scholar] [CrossRef]
- Soria-Segarra, C.; González-Bustos, P.; López-Cerero, L.; Fernández-Cuenca, F.; Rojo-Martín, M.D.; Fernández-Sierra, M.A.; Gutiérrez-Fernández, J. Tracking KPC-3-producing ST-258 Klebsiella pneumoniae outbreak in a third-level hospital in Granada (Andalusia, Spain) by risk factors and molecular characteristics. Mol. Biol. Rep. 2020, 47, 1089–1097. [Google Scholar] [CrossRef]
- Dolejska, M.; Papagiannitsis, C.C. Plasmid-mediated resistance is going wild. Plasmid. 2018, 99, 99–111. [Google Scholar] [CrossRef]
- Pachori, P.; Gothalwal, R.; Gandhi, P. Emergence of antibiotic resistance Pseudomonas aeruginosa in intensive care unit; a critical review. Genes Dis. 2019, 6, 109–119. [Google Scholar] [CrossRef]
- Jiménez-Guerra, G.; Heras-Cañas, V.; Gutiérrez-Soto, M.; Navarro-Marí, J.M.; Gutiérrez-Fernández, J. Urinary tract infection by Acinetobacter baumannii and Pseudomonas aeruginosa: Evolution of antimicrobial resistance and therapeutic alternatives. J. Med. Microbiol. 2018, 67, 790–797. [Google Scholar] [CrossRef]
- Lupo, A.; Haenni, M.; Madec, J.-Y. Antimicrobial Resistance in Acinetobacter spp. and Pseudomonas spp. Microbiol. Spectrum 2018, 6, 1–16. [Google Scholar]
- Sawa, T.; Kooguchi, K.; Moriyama, K. Molecular diversity of extended-spectrum β-lactamases and carbapenemases, and antimicrobial resistance. J. Intensive Care 2020, 8, 13. [Google Scholar] [CrossRef]

| Types of Carbapenemases | Total | |||||||||||||||
|---|---|---|---|---|---|---|---|---|---|---|---|---|---|---|---|---|
| VIM- | KPC- | NDM-5 | IMP- | OXA | ||||||||||||
| −1 | −2 | −2 | −3 | −8 | −16 | −23 | −48 | −23 | −58 | −245 | ||||||
| Enterobacterales | Escherichia coli | 2 | 0 | 0 | 0 | 0 | 0 | 0 | 0 | 2 | 0 | 0 | 0 | 4 | ||
| Enterobacter cloacae | 5 | 0 | 0 | 0 | 0 | 0 | 0 | 0 | 2 | 0 | 0 | 0 | 7 | |||
| Klebsiella oxytoca | 2 | 0 | 1 | 0 | 0 | 0 | 0 | 0 | 0 | 0 | 0 | 0 | 3 | |||
| Klebsiella pneumoniae | 1 | 0 | 0 | 2 | 4 | 1 | 0 | 0 | 13 | 0 | 0 | 1 | 22 | |||
| Citrobacter freundii a | 0 | 1 | 1 | 0 | 0 | 0 | 0 | 0 | 1 | 0 | 0 | 0 | 3 a | |||
| Pseudomonas | P. aeruginosa | 2 | 3 | 0 | 0 | 0 | 12 | 7 | 2 | 0 | 0 | 0 | 0 | 26 | ||
| P. putida | 1 | 1 | 0 | 0 | 0 | 0 | 0 | 0 | 0 | 0 | 0 | 0 | 2 | |||
| Acinetobacter | A. baumannii | 0 | 0 | 0 | 0 | 0 | 0 | 0 | 0 | 0 | 19 | 12 | 0 | 31 | ||
| Total | 13 | 5 | 2 | 2 | 4 | 13 | 7 | 2 | 18 | 19 | 12 | 1 | 98 | |||
| Color of Colonies on ESBL | ||||||||
|---|---|---|---|---|---|---|---|---|
| Microorganisms | Light Beige | Green-Blue | Light Green-Blue | Pink | Light Pink | Light Brown | Brown | Total |
| E. coli ESBL | 1 | 0 | 0 | 54 | 3 | 0 | 0 | 58 |
| E. coli AmpC | 0 | 0 | 0 | 4 | 0 | 0 | 0 | 4 |
| E. coli CAR | 1 | 0 | 0 | 3 | 0 | 0 | 0 | 4 |
| K. pneumoniae ESBL | 0 | 17 | 0 | 0 | 0 | 0 | 0 | 17 |
| K. pneumoniae AmpC | 0 | 1 | 1 | 0 | 0 | 0 | 0 | 2 |
| K. pneumoniae CAR | 0 | 22 | 0 | 0 | 0 | 0 | 0 | 22 |
| P. mirabilis ESBL | 0 | 0 | 0 | 0 | 0 | 2 | 0 | 2 |
| C. freundii AmpC | 1 | 0 | 0 | 0 | 0 | 0 | 0 | 1 |
| C. freundii CAR | 1 | 0 | 0 | 1 | 0 | 0 | 0 | 2 |
| K. aerogenes AmpC | 0 | 1 | 0 | 0 | 0 | 0 | 0 | 1 |
| E. cloacae AmpC | 0 | 0 | 2 | 0 | 0 | 0 | 0 | 2 |
| E. cloacae CAR | 3 | 3 | 1 | 0 | 0 | 0 | 0 | 7 |
| E. gergoviae AmpC | 0 | 0 | 2 | 0 | 0 | 0 | 0 | 2 |
| K. oxytoca CAR | 0 | 0 | 3 | 0 | 0 | 0 | 0 | 3 |
| P. aeruginosa CAR | 14 | 0 | 0 | 0 | 0 | 0 | 12 | 26 |
| P. putida CAR | 2 | 0 | 0 | 0 | 0 | 0 | 0 | 2 |
| A. baumannii CAR | 31 | 0 | 0 | 0 | 0 | 0 | 0 | 31 |
| Total | 54 | 44 | 9 | 62 | 3 | 2 | 12 | 186 |
| Cefepime | Cefoxitin | Total | |||
|---|---|---|---|---|---|
| Susceptible | Resistant | Susceptible | Resistant | ||
| E. coli | 29 (37.7) | 29 (37.7) | 57 (74.0) | 1 * (1.3) | 58 |
| K. pneumoniae | 3 (3.9) | 14 (18.2) | 15 (19.5) | 2 ** (2.6) | 17 |
| P. mirabilis | 2 (2.6) | 0 (0) | 2 (2.6) | 0 (0) | 2 |
| Total | 34 (44.2) | 43 (55.8) | 74 (96.1) | 3 (3.9) | 77 |
© 2020 by the authors. Licensee MDPI, Basel, Switzerland. This article is an open access article distributed under the terms and conditions of the Creative Commons Attribution (CC BY) license (http://creativecommons.org/licenses/by/4.0/).
Share and Cite
Montiel-Riquelme, F.; Calatrava-Hernández, E.; Gutiérrez-Soto, M.; Expósito-Ruiz, M.; Navarro-Marí, J.M.; Gutiérrez-Fernández, J. Clinical Relevance of Antibiotic Susceptibility Profiles for Screening Gram-negative Microorganisms Resistant to Beta-Lactam Antibiotics. Microorganisms 2020, 8, 1555. https://doi.org/10.3390/microorganisms8101555
Montiel-Riquelme F, Calatrava-Hernández E, Gutiérrez-Soto M, Expósito-Ruiz M, Navarro-Marí JM, Gutiérrez-Fernández J. Clinical Relevance of Antibiotic Susceptibility Profiles for Screening Gram-negative Microorganisms Resistant to Beta-Lactam Antibiotics. Microorganisms. 2020; 8(10):1555. https://doi.org/10.3390/microorganisms8101555
Chicago/Turabian StyleMontiel-Riquelme, Francisco, Elisabeth Calatrava-Hernández, Miguel Gutiérrez-Soto, Manuela Expósito-Ruiz, José María Navarro-Marí, and José Gutiérrez-Fernández. 2020. "Clinical Relevance of Antibiotic Susceptibility Profiles for Screening Gram-negative Microorganisms Resistant to Beta-Lactam Antibiotics" Microorganisms 8, no. 10: 1555. https://doi.org/10.3390/microorganisms8101555
APA StyleMontiel-Riquelme, F., Calatrava-Hernández, E., Gutiérrez-Soto, M., Expósito-Ruiz, M., Navarro-Marí, J. M., & Gutiérrez-Fernández, J. (2020). Clinical Relevance of Antibiotic Susceptibility Profiles for Screening Gram-negative Microorganisms Resistant to Beta-Lactam Antibiotics. Microorganisms, 8(10), 1555. https://doi.org/10.3390/microorganisms8101555

